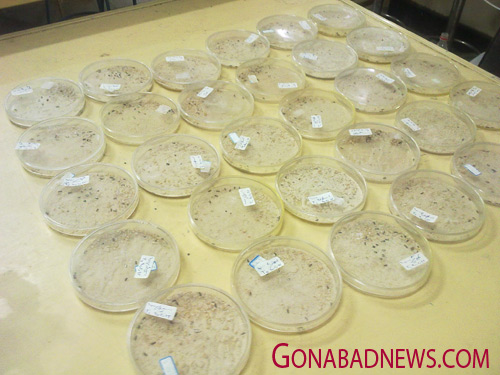

دانش آموز گنابادی در جشنواره خوارزمی
طرح غربالگیری جلبک جهت تهیه حشره کش طبیعی از دانش آموز گنابادی امین عطایی به مرحله دوم کشوری جشنواره خوارزمی راه یافته و منتظر اعلام نتیجه می باشد.
امین عطایی دانش آموز دوم دبیرستان طلایه داران(تیز هوشان گناباد) در مورد این طرح به خبرنگار گناپا اظهار داشت؛ سال گذشته طرح تهیه حشره کش طبیعی از جلبک به جشنواره خوارزمی ارائه شد که این طرح بعد از پذیرفته شدن در مرحله استانی به مرحله اول کشور راه یافت و در آنجا اعضاء هیئت علمی دانشگاه شهید رجائی که در واقع داوران این بخش بودند طرح را تایید و پذیرفتند که طرح به مرحله دوم کشوری نیز راه پیدا کرد و در حال حاضر منتظر اعلام نتیجه در این قسمت هستم که تا پایان آبان ماه اعلام خواهد شد.
وی ادامه داد؛آزمایشات من روی جلبک میکروسیتیس که یک جلبک شورزی می باشد که در کال شور گناباد رشد می کند انجام شده و خاصیت حشره کشی این جلبک در محیط آزمایشگاه به اثبات رسیده و روی شپشک آرد نیز مورد آزمایش قرار گرفته است.
این نوجوان محقق افزود؛ من امیدوارم که این طرح در بخش صنعتی نیز مورد قبول واقع شود و بتوان از آن در تولید حشره کش استفاده کرد بخصوص که حشره کش طبیعی به خاطر عدم تاثیر منفی بر طبیعت بسیار می تواند کار آمد باشد.
عطائی گفت؛حشره کش های موجود در بازار همگی شیمیایی هستند و علاوه بر تاثیرات منفی بر طبیعت برای انسان نیز مضرند در صورتیکه حشره کش طبیعی قابلیت تجزیه در طبیعت را دارد و برای انسان نیز خطری ندارد.
وی افزود؛این طرح فعلا در مقیاس آزمایشگاهی مورد سنجش قرار گرفته و اگر در مقیاس نیمه صنعتی و صنعتی نیز آزمایش آن مثبت باشد می تواند به تولید انبوه برسد.
امین عطائی از شروع یک طرح جدید برای جشنواره امسال خبر داد و گفت؛ این طرح که از اواسط امسال شروع شده در مورد کشت بافت می باشد و تحقیق روی گیاهان دارویی است که تا بحال روی آنها کار نشده است.
وی افزود؛ کشت بافت یک تکنیک است که در آن می توان فقط یک قسمت گیاه را که نیاز است تولید کرد.برای مثال در گیاهی که برگ آن اهمیت دارویی دارد فقط برگ تولید می شود و سایر قسمت های گیاه تولید نمی شود که این روش در محیط آزمایشگاهی امکان پذیر می باشد.
این دانش آموز گنابادی یادآور شد؛ تحقیق و پژوهش باعث بالا رفتن سطح مطالعه در افراد می شود و کسانیکه فکر می کنند اگر به این کارها بپردازند در درس و مدرسه عقب می مانند به نظر من درست نیست چرا که پژوهش در راستای درس است و تناقضی با پیشرفت درسی ندارد. از این رو به همه دوستانم توصیه می کنم به کارهای پژوهشی روی بیاورند چرا که باعث می شود درس خواندن شیرین تر و جالب تر باشد.
مهندس مجید دانا استاد راهنمای امین عطایی در این طرح در ادامه این گفتگو تصریح کرد،هر ساله حداقل یک طرح از زیست شناسی به مرحله کشوری راه پیدا می کند و این به خاطر تلاش گروهی افرادیست که در گروه زیست شناسی فعالیت می کنند که از آن جمله دکتر داور پناه،خانم جوادی،آقای فردوسی،خانم عشقی،خانم پیشکار و دکتر صفرنژاد را می توان نام برد ضمن آنکه برخی از اعضای هیئت علمی دانشگاه آزاد نیز در تیم ما حضور دارند و این کار گروهی باعث ثمر بخشی و موفقیت دانش آموزان گنابادی شده است.
وی افزود؛ در حال حاضر ۶ سال از فعالیت پژوهش سرای دانش آموزی پیامبر اعظم (ص) می گذرد و با توجه به جو کلی جامعه که چندان به تحقیقات اهمیت داده نمی شود،امیدوارم مسئولین و رسانه ها از کسانیکه وارد عرصه تحقیقات می شوند بیشتر حمایت کنند.
مهندس دانا یاد آور شد؛ در حال حاضر برای دبیران تربیت بدنی که موفق به استعدادیابی در دانش آموزان می شوند و آنها را به یک رشته یا یک تیم ورزشی معرفی می کنند.تشویق و پاداش های قابل توجهی در نظر گرفته می شود و اگر این تشویق ها در بخش تحقیق و پژوهش نیز باشد باعث دلگرمی معلمین و دبیران خواهد شد و آنها انگیزه بیشتری برای تشویق دانش آموزان در امر پژوهش خواهند داشت.
وی تصریح کرد؛ پژوهش سرای دانش آموزی پیامبر اعظم (ص) از تمام دانش آموزانی که علاقه مند به تحقیق و پژوهش هستند استقبال می کند و ما امیدواریم دانش آموزان به امر تحقیق و پژوهش بیشتر توجه کنند.

مبارک صاحبش باشه